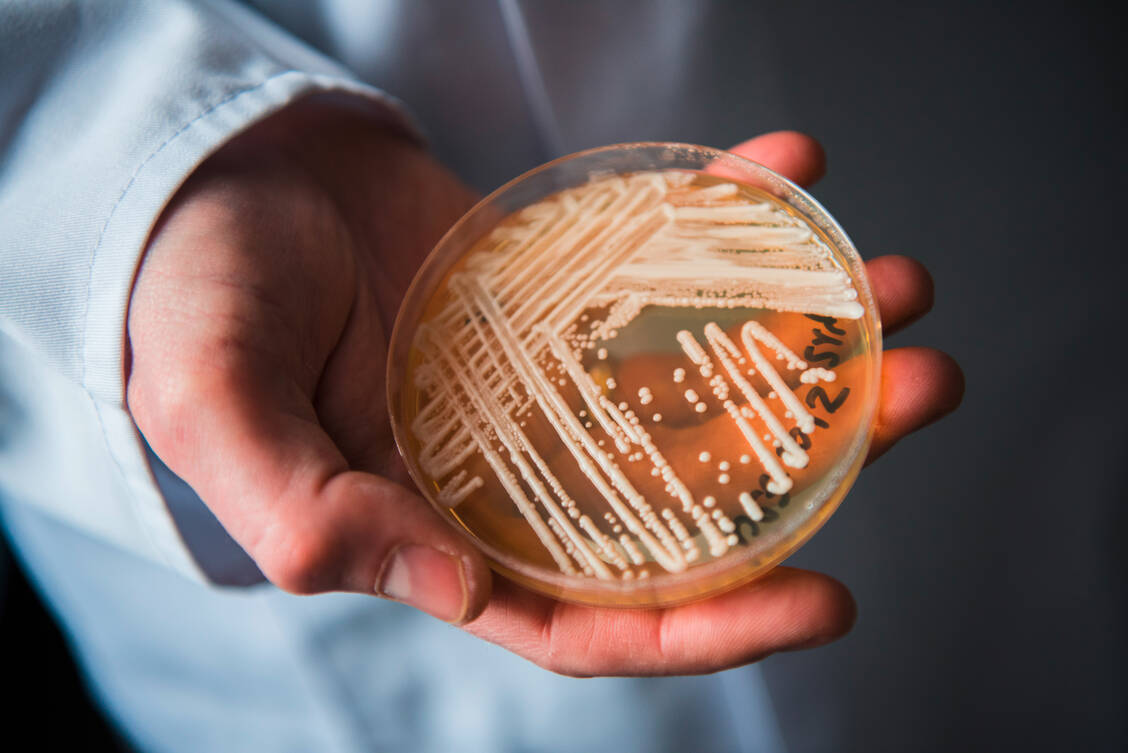

Das erste Mal trat C. auris 2009 in Japan in Erscheinung. Damals wurde er im Ohrabstrich einer Patientin entdeckt und vom Mikrobiologen Kazuo Satoh C. auris –vom lateinischen Wort für Ohr – genannt. Zeitgleich traten auch in Südkorea Infektionen auf und später auch in weit auseinander liegenden Regionen der Welt wie Indien, Südafrika, Brasilien und Spanien. Verbindungen zwischen den betroffenen Patienten gab es vermutlich nicht. Es stellte sich zudem heraus, dass sich die Pilze genetisch von Kontinent zu Kontinent unterscheiden. Das lässt ausschließen, dass sich C. auris von einem Land aus weiterverbreitet hat. Vielmehr scheint sich der Pilz zeitgleich in verschiedenen Regionen so verändert zu haben, dass er Menschen infizieren kann.